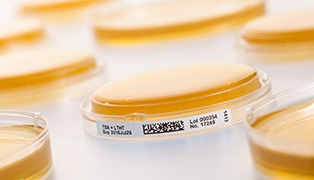
寒天培地

培地の種類
①環境モニタリング用培地
無菌医薬品製造区域がそれぞれ設計された清浄度、微生物制御を達成し、維持していることを確認するための培地です。
環境下の落下菌・浮遊菌・付着菌を確認します。
②無菌試験用培地
無菌であることが求められている原薬又は製剤に適応される無菌試験で使用する培地です。主に液体培地が用いられます。

EP、USP、JP各薬局方に対応した
独・ファーマメディア社製の高品質な
環境モニタリング用培地、無菌試験用培地のご案内。
無菌医薬品製造区域がそれぞれ設計された清浄度、微生物制御を達成し、維持していることを確認するための培地です。
環境下の落下菌・浮遊菌・付着菌を確認します。
無菌であることが求められている原薬又は製剤に適応される無菌試験で使用する培地です。主に液体培地が用いられます。
GMPに準拠し、微生物管理された医薬品製造グレードAで製造を行い、コンタミネーションリスクを排除しています。
また、各バッチ毎に原材料の検査を厳密に行っています。



自家調製している培地の配合(レシピ)を少量でも製造対応が可能です。
より効果的な殺菌剤の不活性化のご提案や配合変更はもちろん、ボトルサイズや容量変更などの
ご要望に合わせたカスタマイズも行いますので、お気軽にご相談ください。
自社での培地調製作業やバッチ毎の性能試験が不要。
人手不足の環境下で、非常に有益で、削減された工数・時間を他業務に有効活用できます。
環境に合わせた培地を使用することで偽陰性のリスクが最小限に抑えられ、結果的に
検査精度の向上が図れます。
高度衛生環境の維持・運用には局方で規定される室内環境の殺菌が必要でありますが、一般的に殺菌後の室内環境には殺菌剤の残留があることが知られています。
そのため環境モニタリング実施時に培地が残留殺菌剤に接触することにより、例え微生物が存在したとしても、プレート上の残留殺菌剤によって殺菌されてしまうため陰性と判断される事があります。
これを偽陰性と呼び、環境モニタリングを行う上で大きな問題となります。
偽陰性リスクを排除し正確な検査データを得るには、残留殺菌剤を不活性化させる必要があり、中和剤が添加された培地のご使用をお奨めしています。
しかし、中和剤が添加されていればどんなものでも不活性化するものではありません。
殺菌剤ごとに添加する中和剤の種類や配合は異なり、また2種類以上の消毒剤や殺菌剤を使用する場合などもあることから、環境に合わせた培地が必要となります。

ロック機構付キャップ

スクリューキャップ、フリップキャップ
| 品番 | 品名 | 入数/箱 | 使用期限 |
|---|---|---|---|
| コンタクトプレート (ガンマ線照射済み/3重包装) | |||
| 100.0100 | TSA w. LTHT Contact Plate CSG | 100 | 9ヶ月 |
| 114.0100 | TSA + LTG+β-Lac 2G | 100 | 8ヶ月 |
| 101.0100 | TSA U+ | 100 | 9ヶ月 |
| 120.0100 | SDA w. LTHT Contact Plate CSG | 100 | 8ヶ月 |
| 118.0100* | TSA w.LT Contact Plate CSG | 100 | 9ヶ月 |
| 116.0100 | TSA +LT+β-Lac l/ll | 100 | 8ヶ月 |
| 117.0100* | TSA+Penase | 100 | 8ヶ月 |
| 121.0100* | SDA selective + LTHT | 100 | 8ヶ月 |
| 122.0100* | SDA-U+ | 100 | 8ヶ月 |
| 90mm シャーレ (ガンマ線照射済み/3重包装) | |||
| 203.0060* | TSA U+ | 60 | 9ヶ月 |
| 200.0060 | TSA + LTHT CSG | 60 | 9ヶ月 |
| 218.0060* | TSA + LT CSG 90 mm | 60 | 9ヶ月 |
| 210.0060 | TSA 90mm Plate CSG | 60 | 9ヶ月 |
| 216.0060 | TSA + LT + B-Lac l/ll CSG | 60 | 8ヶ月 |
| 217.0060* | TSA w. Penase CSG | 60 | 6ヶ月 |
| 214.0060 | TSA w. LTG + BLactamasePlus CSG | 60 | 8ヶ月 |
| 220.0060 | SDA w. LTHT 90mm CSG | 60 | 8ヶ月 |
| 221.0060* | SDA Selective w. LTHT CSG | 60 | 8ヶ月 |
| 225.0060* | SDA | 60 | 8ヶ月 |
| コンタクトプレート (非ガンマ線照射/1重包装) | |||
| 300.0120 | TSA w. LTH CS | 120 | 9ヶ月 |
| 90mm シャーレ (非ガンマ線照射/1重包装) | |||
| 400.0060 | TSA w. LTH 90mm Plate CS | 60 | 9ヶ月 |
| 410.0060 | TSA 90mm Plate CS | 60 | 9ヶ月 |
| 411.0060* | TSA 90mm Plate CS 22ml | 60 | 9ヶ月 |
| 426.0060 | SDA w. 90mm Plate CS | 60 | 8ヶ月 |
| 427.0060* | SDA 22ml | 60 | 6ヶ月 |
| 425.0060 | SDA + Chloramphenicol | 60 | 8ヶ月 |
| 450.0060 | Cetrimid Agar 24ml | 60 | 6ヶ月 |
| 455.0060 | Mannitol 24ml | 60 | 6ヶ月 |
| 460.0060 | McConkey 24ml | 60 | 6ヶ月 |
| 465.0060 | VRBD 24ml | 60 | 6ヶ月 |
| 470.0060 | XLD 24ml | 60 | 4ヶ月 |
| 490.0060 | R2A 90mm CS | 60 | 8ヶ月 |
| 液体培地・洗浄液 (スクリューキャップ/口径 約32mm/針差込口3か所) | |||
| 571.B090 | Phosphate Buffer - Na (NOB) | 12 | 12ヶ月 |
| 578.D000 | NACL Peptone Buffer, 1000ml | 6 | 12ヶ月 |
| 500.B100 | TSB 100ml | 12 | 12ヶ月 |
| 501.B090 | TSB 90ml | 12 | 12ヶ月 |
| 502.B135 | TSB 135ml | 12 | 12ヶ月 |
| 503.B200 | TSB 200ml | 12 | 12ヶ月 |
| 505.D000 | TSB 1000ml | 6 | 12ヶ月 |
| 542.D000 | Fluid A 1000ml | 6 | 12ヶ月 |
| 552.D000* | Fluid D 1000ml | 6 | 12ヶ月 |
| 566.B090 | NPB + Tween 80 (0,1%) 90ml | 12 | 12ヶ月 |
| 571.B090 | NaCl-Pepton-Puffer 90ml | 12 | 12ヶ月 |
| 573.B200 | NPB + Tween 80 (0,1%) 200ml | 12 | 12ヶ月 |
| 580.B100 | Sab.-Gluc.-Bouillon 100ml | 12 | 12ヶ月 |
| 581.B100 | McConkey Bouillon 100ml | 12 | 9ヶ月 |
| 600.B200 | TSA 200ml | 12 | 12ヶ月 |
| 601.B200 | SDA 200ml | 12 | 9ヶ月 |
| 602.B200* | SDA + CA 200ml | 12 | 9ヶ月 |
| 603.B200* | R2A Agar 200ml | 12 | 10ヶ月 |
| 液体培地・洗浄液 (フリップキャップ/口径 約22mm) | |||
| 520.S100 | TSB 100ml | 20 | 12ヶ月 |
| 530.S100 | Thioglykolat (FTM) Clear 100ml | 20 | 12ヶ月 |
| 540.S100 | Fluid A 100ml | 20 | 12ヶ月 |
| 550.S100 | Fluid D 100ml | 20 | 12ヶ月 |
| 543.U300* | Fluid A 300ml in 500ml bottle | 8 | 12ヶ月 |
| 553.U300 | Fluid D 300ml in 500ml bottle | 8 | 12ヶ月 |
* 受注生産品です。詳細はお問合せください。
最低発注数量の目安:寒天培地 6箱以上/液体培地 別途お問合せください。
その他、ガンマ線照射済みバッグ・オリジナルプラスチックシャーレ等の製品もございます。
無菌環境ソリューションに関する
お問い合わせ・ご相談はこちら